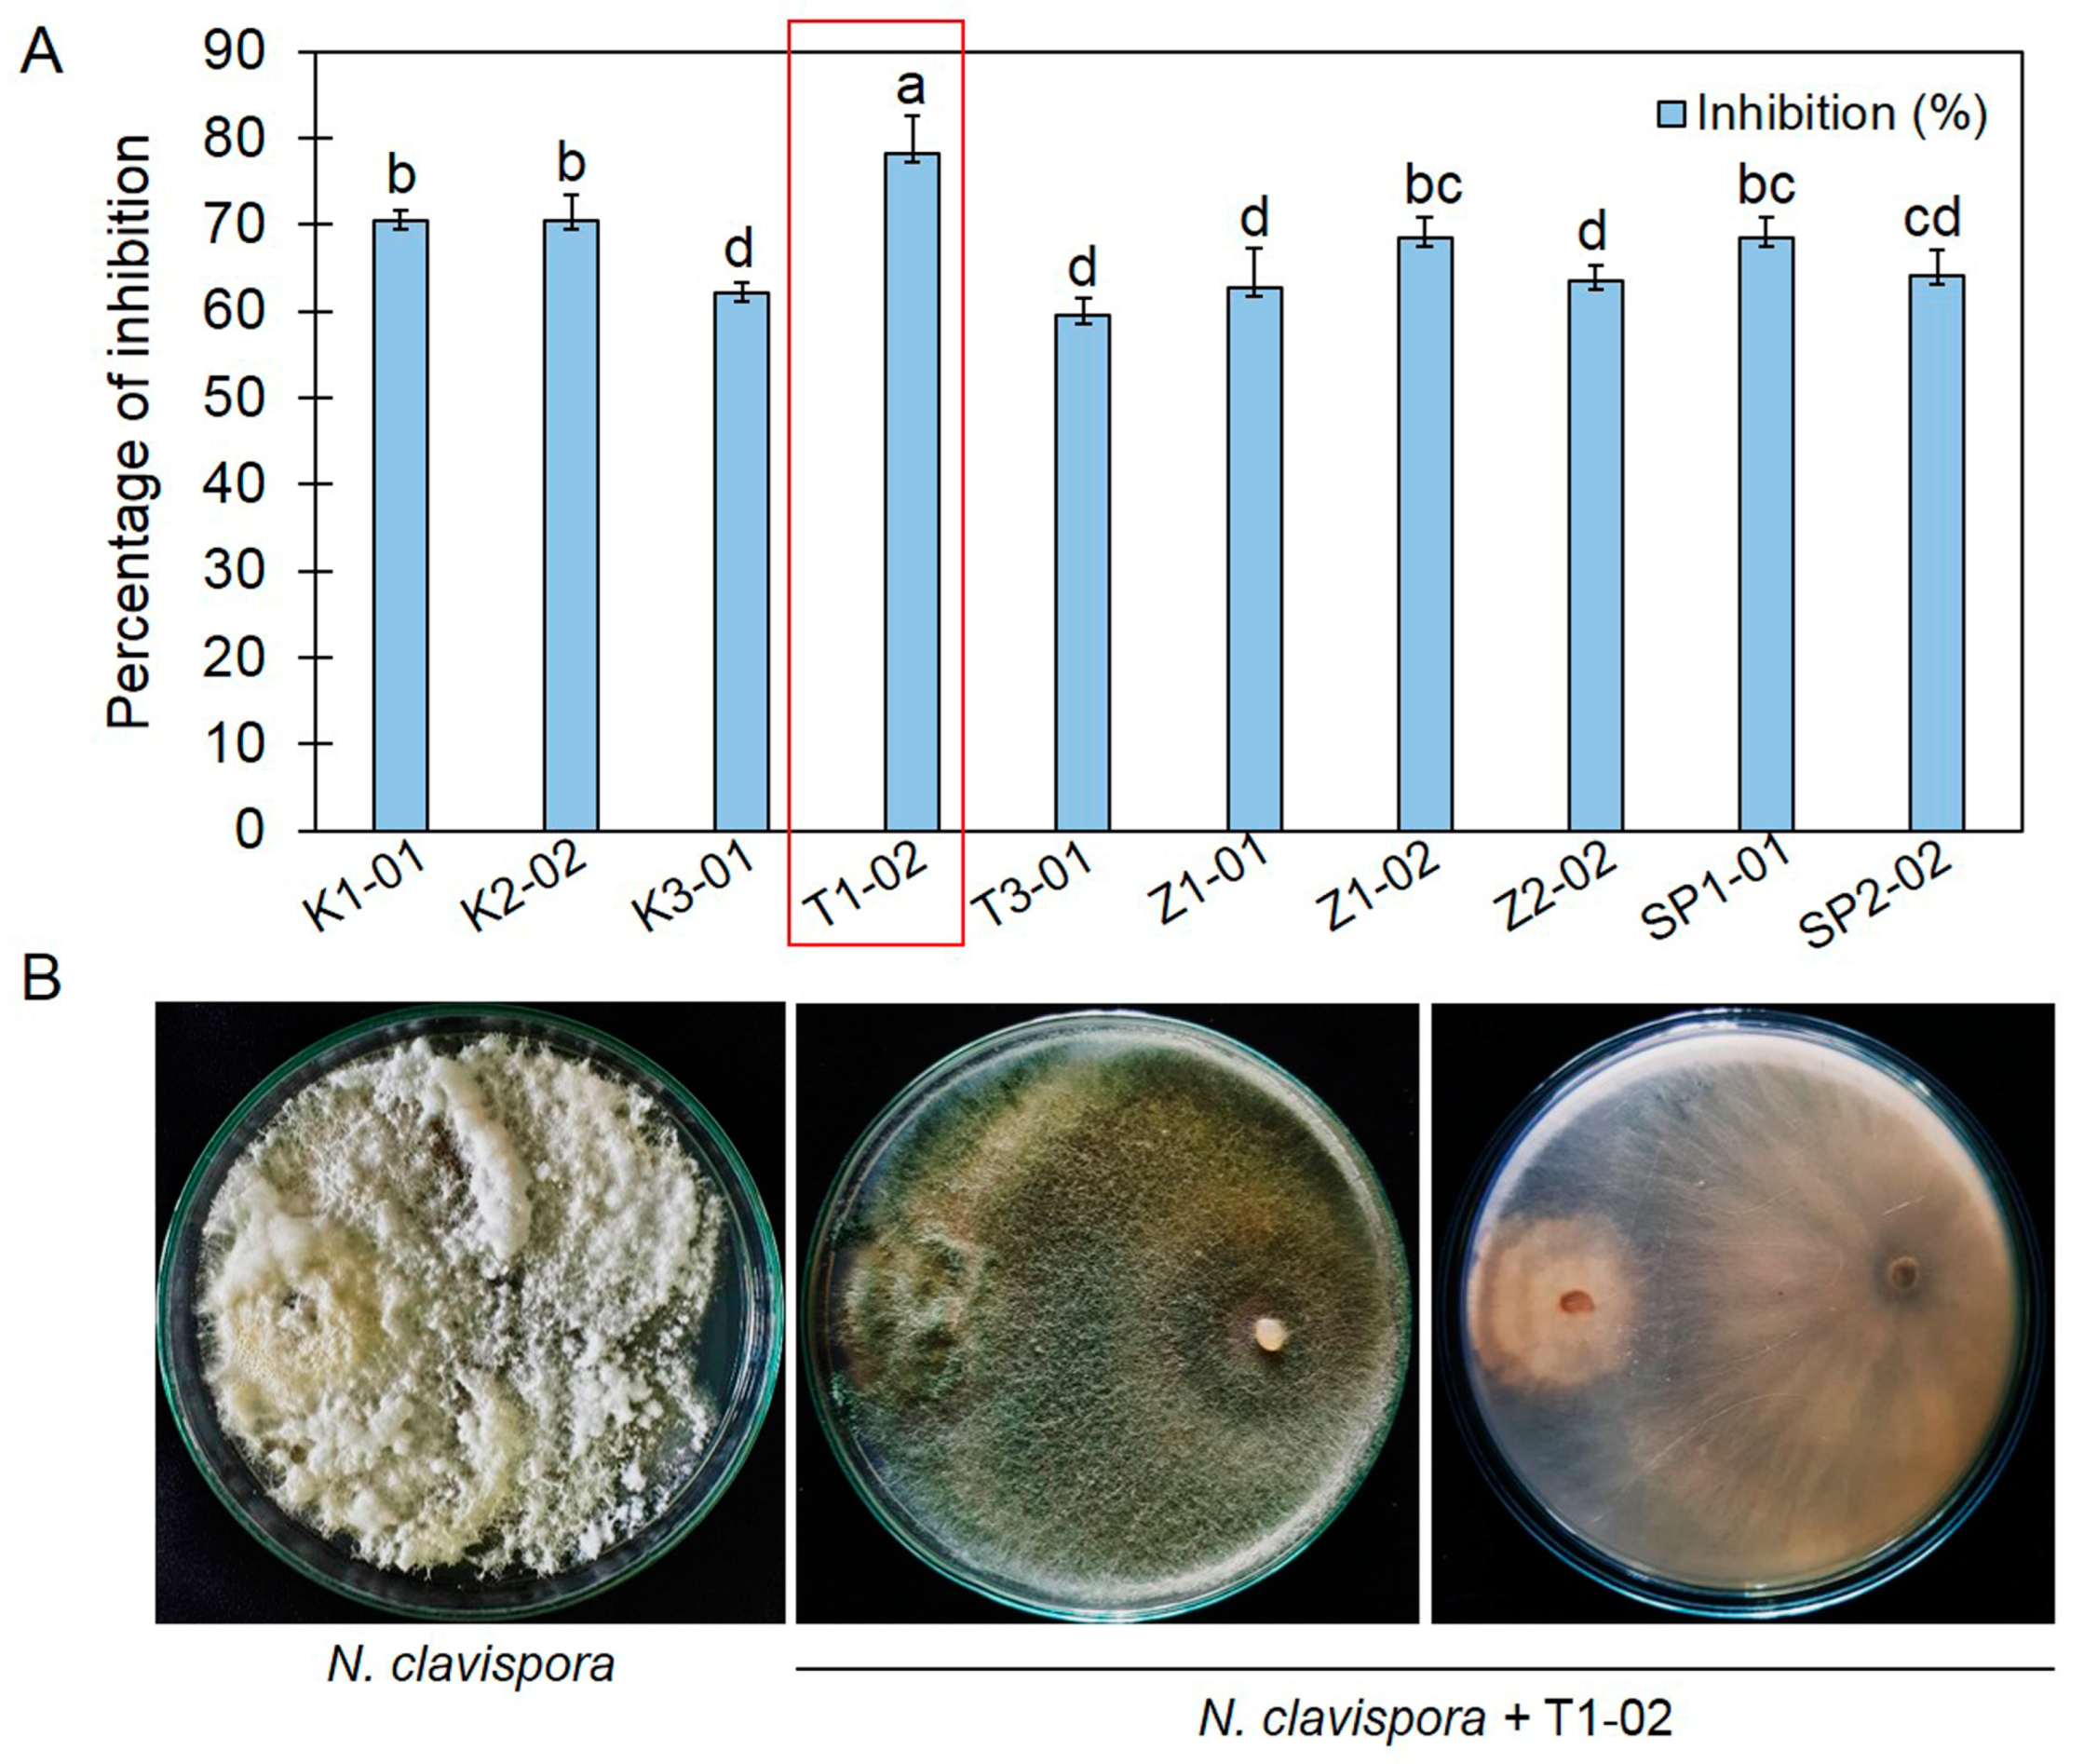
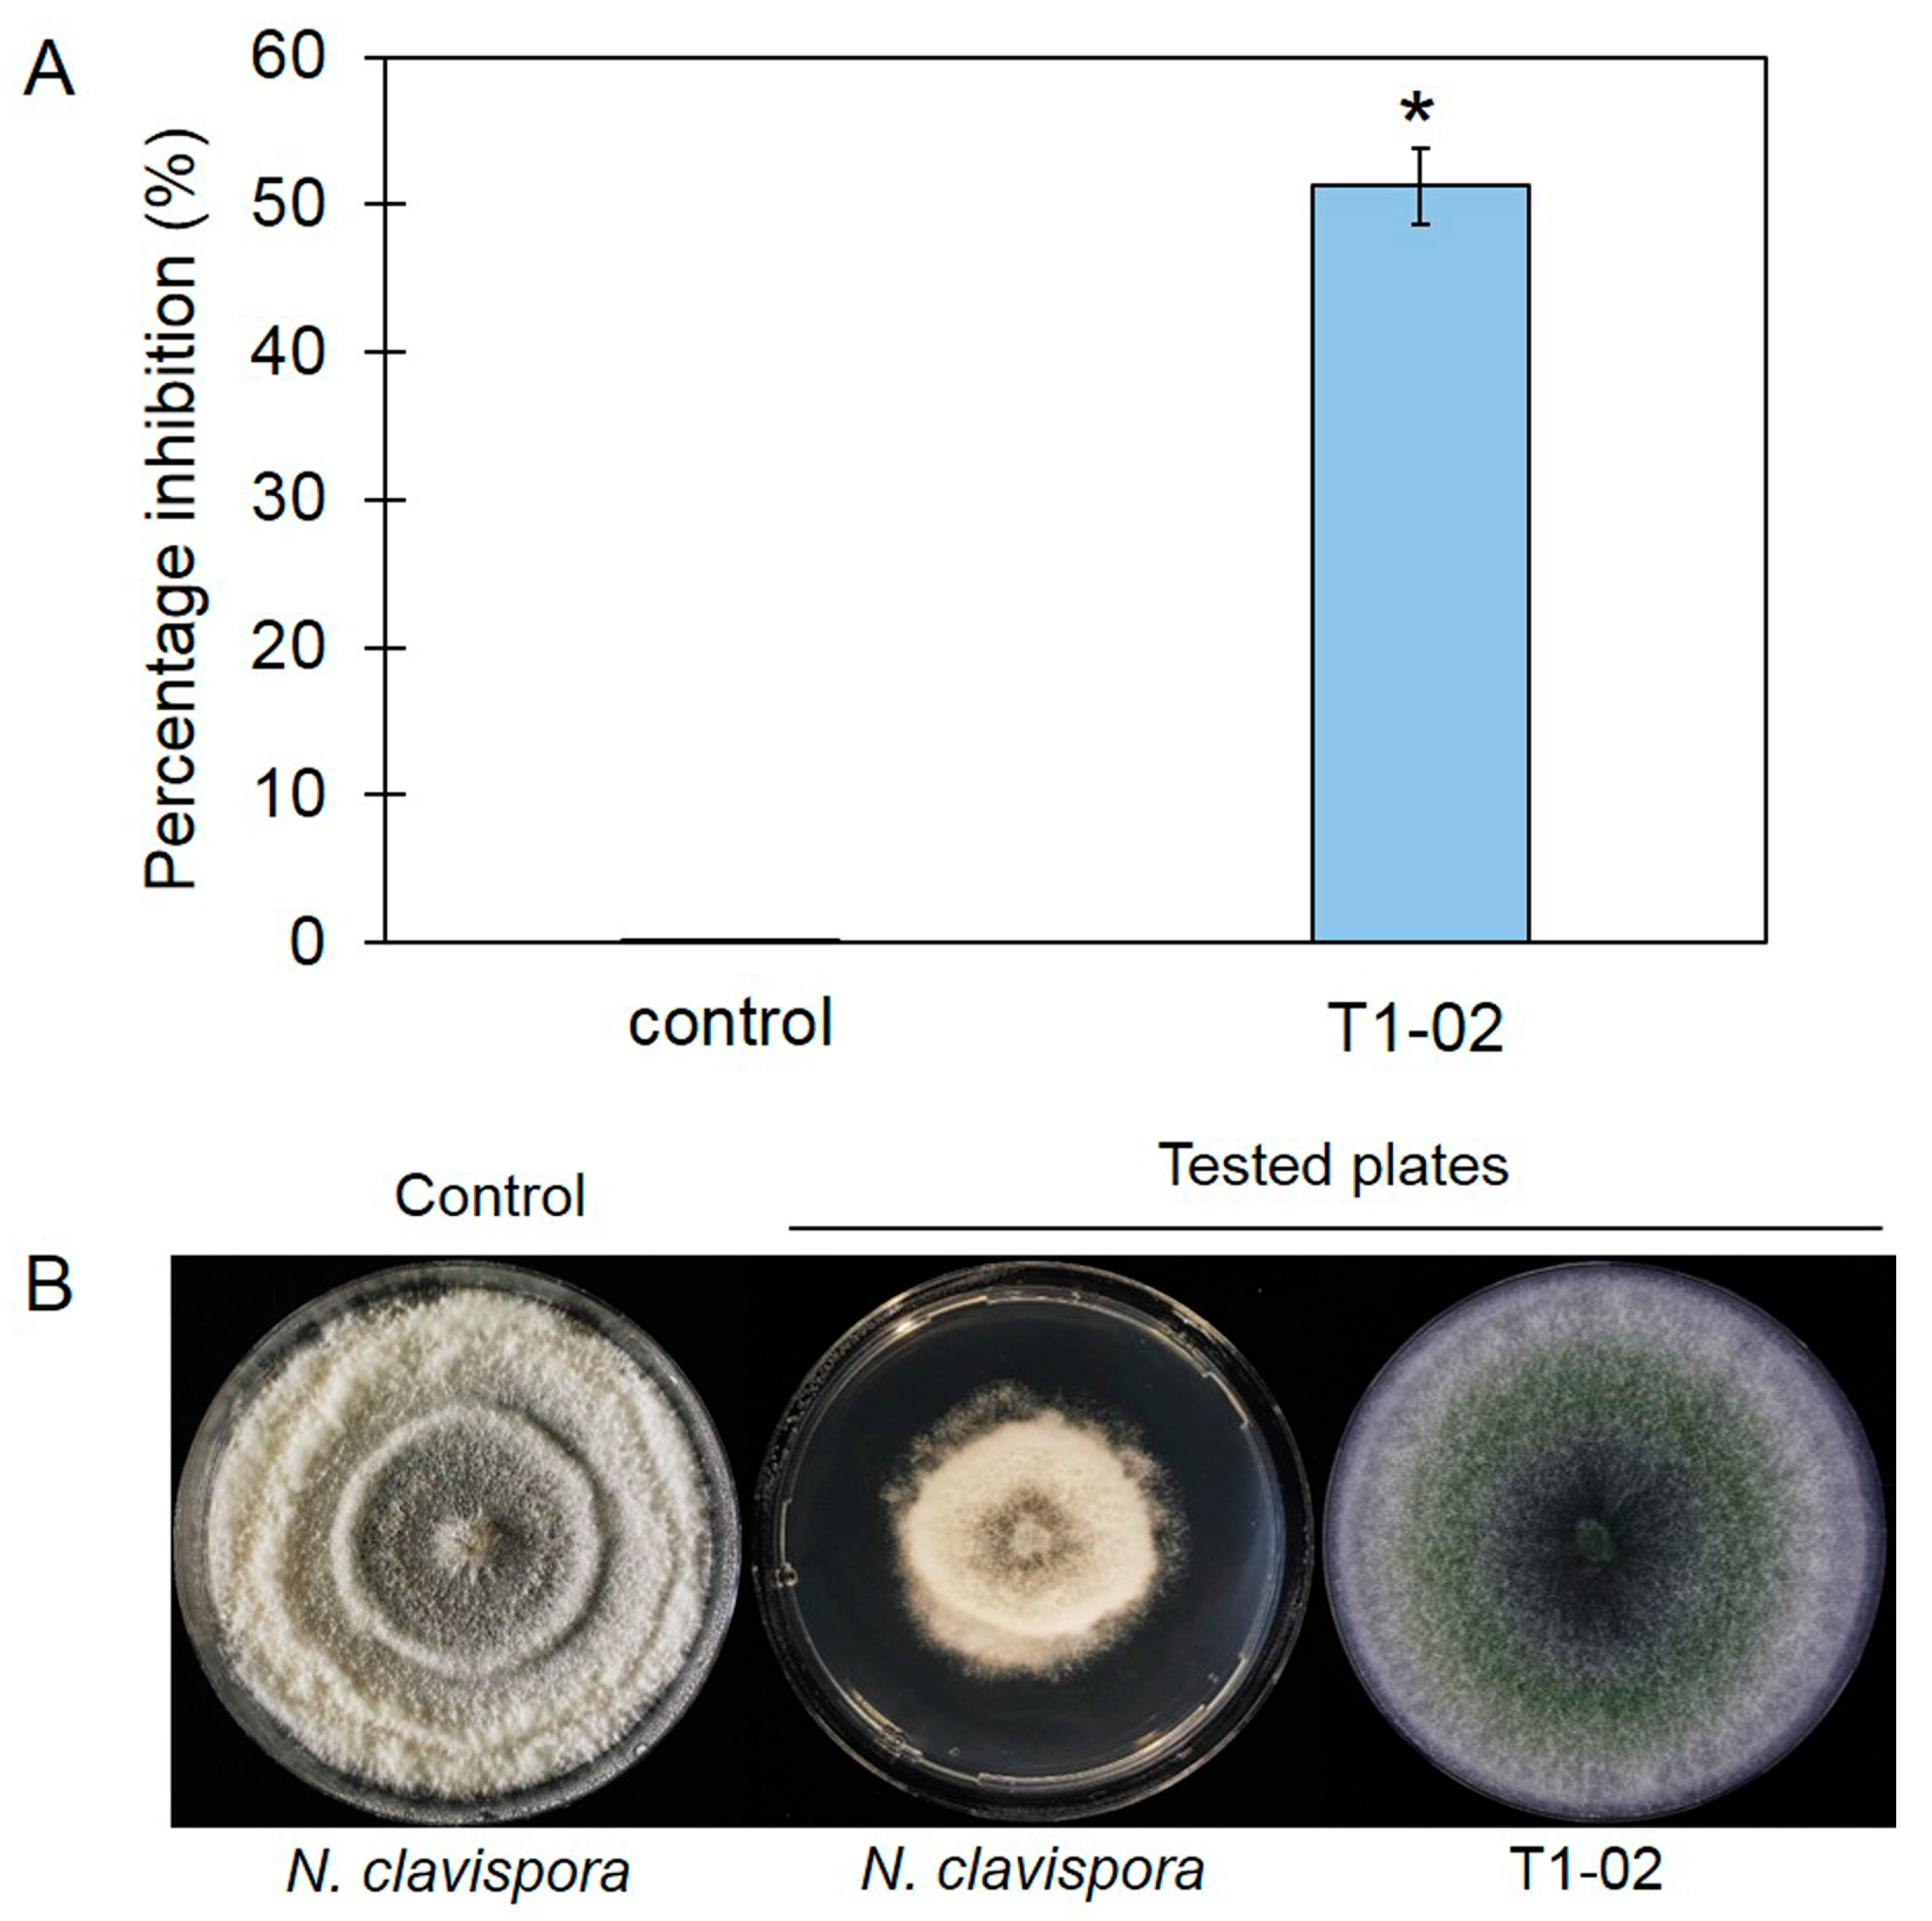

Biological Control Activities of Rhizosphere Fungus Trichoderma virens T1-02 in Suppressing Flower Blight of Flamingo Flower (Anthurium andraeanum Lind.)
Abstract
1. Introduction
2. Materials and Methods
2.1. Fungal Strains
2.2. Dual Culture Assay
2.3. Identification of Trichoderma Species
2.4. Volatile Antifungal Bioassay
2.5. Solid-Phase Microextraction (SPME) Gas Chromatography–Mass Spectrometry (GC/MS) Analysis
2.6. Pre-Colonized Plate Method
2.7. In Vivo Test
2.8. Statistical Analysis
3. Results
3.1. Primary Screening of Trichoderma spp., against Neopestalotiopsis clavispora
3.2. Identification of Trichoderma Strain T1-02
3.3. Production of Volatile Antifungal Compounds
3.4. Mycoparasitic Properties of Trichoderma T1-02
3.5. Trichoderma virens T1-02 Suppressed Symptom Development
4. Discussion
5. Conclusions
Author Contributions
Funding
Institutional Review Board Statement
Informed Consent Statement
Data Availability Statement
Acknowledgments
Conflicts of Interest
References
- Hartmann, A.; Rothballer, M.; Schmid, M. Lorenz Hiltner, A pioneer in rhizosphere microbial ecology and soil bacteriology research. Plant Soil 2008, 312, 7–14. [Google Scholar] [CrossRef]
- Hinsinger, P.; Bengough, G.A.; Vetterlein, D.; Young, I.M. Rhizosphere: Biophysics, biogeochemistry and ecological relevance. Plant Soil 2009, 321, 117–152. [Google Scholar] [CrossRef]
- Lambers, H.; Mougel, C.; Jaillard, B.; Hinsinger, P. Plant-microbe-soil interactions in the rhizosphere: An evolutionary perspective. Plant Soil 2009, 321, 83–115. [Google Scholar] [CrossRef]
- Raaijmakers, J.M.; Paulitz, T.C.; Steinberg, C.; Alabouvette, C.; Moenne-Loccoz, Y. The rhizosphere: A playground and battlefield for soilborne pathogens and beneficial microorganisms. Plant Soil 2009, 321, 341–361. [Google Scholar] [CrossRef]
- Ehrmann, J.; Ritz, K. Plant: Soil interactions in temperate multi-cropping production systems. Plant Soil 2014, 376, 1–29. [Google Scholar] [CrossRef]
- Phoka, N.; Pornsuriya, C.; Sunpapao, A. High-throughput sequencing provides insight into soil fungal community structure and diversity in plant protected areas of Songkhla zoo in southern Thailand. Chiang Mai J. Sci. 2022, 49, 524–537. [Google Scholar] [CrossRef]
- Verma, M.; Brar, S.K.; Tyagi, R.D.; Surampalli, R.Y.; Valero, J.R. Dissolved oxygen as principal parameter for conidia production of biocontrol fungi Trichoderma viride in non-Newtonian wastewater. J. Ind. Microbiol. Biotechnol. 2006, 33, 941–952. [Google Scholar] [CrossRef]
- Tseng, Y.-H.; Rouina, H.; Groten, K.; Rajani, P.; Furch, A.C.U.; Reichelt, M.; Baldwin, I.T.; Nataraja, K.N.; Uma Shaanker, R.; Oelmüller, R. An Endophytic Trichoderma strain promotes growth of its hosts and defends against pathogen attack. Front. Plant Sci. 2020, 11, 573670. [Google Scholar] [CrossRef]
- Sunpapao, A.; Chairin, T.; Ito, S. The biocontrol by Streptomyces and Trichoderma of leaf spot disease caused by Curvularia oryzae in oil palm seedlings. Biol. Control. 2018, 123, 36–42. [Google Scholar] [CrossRef]
- Bailey, B.A.; Bae, H.; Strem, M.D.; Crozier, J.; Thomas, S.E.; Samuels, G.J.; Vinyard, B.T.; Holmes, K.A. Antibiosis, mycoparasitism, and colonization success for endophytic Trichoderma isolates with biological control potential in Theobroma cacao. Biol. Control 2008, 46, 24–35. [Google Scholar] [CrossRef]
- Phoka, N.; Suwannarach, N.; Lumyong, S.; Ito, S.; Matsui, K.; Arikit, S.; Sunpapao, A. Role of volatiles from the endophytic fungus Trichoderma asperelloides PSU-P1 in biocontrol potential and in promoting the plant growth of Arabidopsis thaliana. J. Fungi 2020, 6, 341. [Google Scholar] [CrossRef]
- Suebrasri, T.; Somteds, A.; Harada, H.; Kanokmedhakul, S.; Jogloy, S.; Ekprasert, J.; Lumyong, S.; Boonlue, S. Novel endophytic fungi with fungicidal metabolites suppress sclerotium disease. Rhizosphere 2020, 16, 100250. [Google Scholar] [CrossRef]
- Intana, W.; Kheawleng, S.; Sunpapao, A. Trichoderma asperellum T76-14 released volatile organic compounds against postharvest fruit rot in muskmelons (Cucumis melo) caused by Fusarium incarnatum. J. Fungi 2021, 7, 46. [Google Scholar] [CrossRef] [PubMed]
- Ruangwong, O.-U.; Wonglom, P.; Phoka, N.; Suwannarach, N.; Lumyong, S.; Ito, S.-I.; Sunpapao, A. Biological control activity of Trichoderma asperelloides PSU-P1 against gummy stem blight in muskmelon (Cucumis melo). Physiol. Mol. Plant Pathol. 2021, 115, 101663. [Google Scholar] [CrossRef]
- Intana, W.; Kumla, J.; Suwannarach, N.; Sunpapao, A. Biological control potential of a soil fungus Trichoderma asperellum K1-02 against Neoscytalidium dimidiatum causing stem canker of dragon fruit. Physiol. Mol. Plant Pathol. 2023, 128, 102151. [Google Scholar] [CrossRef]
- Intana, W.; Wonglom, P.; Suwannarach, N.; Sunpapao, A. Trichoderma asperelloides PSU-P1 induced expression of pathogenesis-related protein genes against gummy stem blight of muskmelon (Cucumis melo) in field evaluation. J. Fungi 2022, 8, 156. [Google Scholar] [CrossRef] [PubMed]
- Zhang, S.; Gan, Y.; Xu, B. Application of plant-growth-promoting fungi Trichoderma longibrachiatum T6 enhances tolerance of wheat to salt stress through improvement of antioxidative defense system and gene expression. Front. Plant Sci. 2016, 7, 1045. [Google Scholar] [CrossRef]
- Galletti, S.; Burzi, P.L.; Cerato, C.; Marinello, S.; Sala, E. Trichoderma as a potential biocontrol agent for Cercospora leaf spot of sugar beet. BioControl 2008, 53, 917–930. [Google Scholar] [CrossRef]
- Chaves, T.P.; Miranda, A.R.G.S.; da Paz, L.C.; Netto, M.S.B.; Lima, G.S.A.; Assunção, I.P. First report of Colletotrichum theobromicola causing anthracnose on Anthurium sp. Australas. Plant Dis. Notes 2020, 15, 27. [Google Scholar] [CrossRef]
- Ben, H.-Y.; Zhao, Y.-J.; Chai, A.-L.; Shi, Y.-X.; Xie, X.-W.; Li, B.-J. First Report of Myrothecium roridum Causing Leaf Spot on Anthurium andraeanum in China. J. Phytopathol. 2015, 163, 144–147. [Google Scholar] [CrossRef]
- Park, M.-J.; Back, C.-G.; Park, J.-H. Occurrence of Phytopythium vixans causing stem rot on Anthurium andraeanum in Korea. Korean J. Mycol. 2019, 47, 443–446. [Google Scholar]
- Daengsuwan, W.; Wonglom, P.; Sunpapao, A. First report of Lasiodiplodia theobromae causing spadix rot in Anthurium andraeanum. J. Phytopathol. 2020, 168, 129–133. [Google Scholar] [CrossRef]
- Daengsuwan, W.; Wonglom, P.; Arikit, S.; Sunpapao, A. Morphological and molecular identification of Neopestalotiopsis clavispora causing flower blight on Anthurium andraeanum in Thailand. Hortic. Plant J. 2021, 7, 573–578. [Google Scholar] [CrossRef]
- Poole, N.F.; Arnaudin, M.E. The role of fungicides for effective disease management in cereal crops. Can. J. Plant Pathol. 2014, 36, 1–11. [Google Scholar] [CrossRef]
- Hahn, M. The rising threat of fungicide resistance in plant pathogenic fungi: Botrytis as a case study. J. Chem. Biol. 2014, 7, 133–141. [Google Scholar] [CrossRef] [PubMed]
- Polat, B.; Tiryaki, O. Determination of fungicide residues in soil using QuEChERS coupled with LC-MS/MS, and environmental risk assessment. Environ. Monit. Assess. 2023, 195, 986. [Google Scholar] [CrossRef]
- Tao, H.; Bao, Z.; Jin, C.; Miao, W.; Fu, Z.; Jin, Y. Toxic effects and mechanisms of three commonly used fungicides on the human colon adenocarcinoma cell line Caco-2. Environ. Pollut. 2020, 263, 114660. [Google Scholar] [CrossRef]
- Rahman, M.A.; Begum, M.F.; Alam, M.F. Screening of Trichoderma isolates as a biological control agent against Ceratocystis paradoxa causing pineapple disease of sugarcane. Microbiology 2009, 37, 277–285. [Google Scholar]
- Saitoh, K.; Togashi, K.; Arie, T.; Teraoka, T. A simple method for a mini-preparation of fungal DNA. J. Gen. Plant Pathol. 2006, 72, 348–350. [Google Scholar] [CrossRef]
- White, T.J.; Bruns, T.; Lee, S.; Tayler, J. Amplification and direct sequencing of fungal ribosomal RNA genes for phylogenies. In PCR Protocols: A Guide to Methods and Applications; Innis, A.M., Gelfelfard, D.H., Snindky, J.J., White, T.J., Eds.; Academic Press: San Diego, CA, USA, 1990; pp. 315–322. [Google Scholar]
- Carbone, I.; Kohn, L.M. A method for designing primer sets for speciation studies in filamentous ascomycetes. Mycologia 1999, 91, 553–556. [Google Scholar] [CrossRef]
- O’Donnell, K.; Kistler, H.C.; Cigelnik, E.; Ploetz, R.C. Multiple evolutionary origins of the fungus causing Panama disease of banana: Concordant evidence from nuclear and mitochondrial gene genealogies. Proc. Nat. Acad. Sci. USA 1998, 95, 2044–2049. [Google Scholar] [CrossRef]
- Liu, Y.J.; Whelen, S.; Hall, B.D. Phylogenetic relationships among ascomycetes: Evidence from and RNA polymerase II subunit. Mol. Biol. Evol. 1999, 16, 1799–1808. [Google Scholar] [CrossRef] [PubMed]
- Hall, T.A. BioEdit: A User-Friendly Biological Sequence Alignment Editor and Analysis Program for Windows 95/98/NT. Nucleic Acids Symp. Ser. 1999, 41, 95–98. [Google Scholar]
- Zeng, X.-Y.; Yuan, X.-X.; Peng, K.-Q.; Pan, Y.-T.; Tan, T.-J.; Wu, N.; Tian, F.-H. Taxonomy and control of Trichoderma hymenopellicola sp. nov. responsible for the first green mold disease on Hymenopellis raphanipes. Front. Microbiol. 2022, 13, 991987. [Google Scholar] [CrossRef] [PubMed]
- Katoh, K.; Rozewicki, J.; Yamada, K.D. MAFFT online service: Multiple sequence alignment, interactive sequence choice and visualization. Brief Bioinform. 2019, 20, 1160–1166. [Google Scholar] [CrossRef]
- Stamatakis, A. RAxML version 8: A tool for phylogenetic analysis and post-analysis of large phylogenies. Bioinformatics 2014, 30, 1312–1313. [Google Scholar] [CrossRef]
- Miller, M.A.; Pfeiffer, W.; Schwartz, T. Creating the CIPRES Science Gateway for Inference of Large Phylogenetic Trees; Gateway Computing Environments Workshop (GCE): New Orleans, LA, USA, 2010; pp. 1–8. [Google Scholar]
- Nylander, J.A.A. MrModeltest Version 2. Program Distributed by the Author; Evolutionary Biology Centre, Uppsala University: Uppsala, Sweden, 2004. [Google Scholar]
- Ronquist, F.; Teslenko, M.; van der Mark, P.; Ayres, D.L.; Darling, A.; Höhna, S.; Larget, B.; Liu, L.; Suchard, M.A.; Huelsenbeck, J.P. MrBayes 3.2: Efficient Bayesian phylogenetic inference and model choice across a large model space. Syst Biol. 2012, 61, 539–542. [Google Scholar] [CrossRef]
- Dennis, C.; Webster, J. Antagonistic properties of species-groups of Trichoderma, II. Production of volatile antibiotic. Trans. Br. Mycol. Soc. 1971, 57, 41–48. [Google Scholar] [CrossRef]
- Ruangwong, O.-U.; Wonglom, P.; Suwannarach, N.; Kumla, J.; Thaochan, N.; Chomnunti, P.; Pitija, K.; Sunpapao, A. Volatile organic compound from Trichoderma asperelloides TSU1: Impact on plant pathogenic fungi. J. Fungi 2021, 7, 187. [Google Scholar] [CrossRef]
- Takaku, Y.; Suzuki, S.; Ohta, I.; Ishii, D.; Muranaka, Y.; Shimomura, M.; Hariyama, T. A thin polymer membrane, nano-suit, enhancing survival across the continuum between air and high vacuum. Proc. Natl. Acad. Sci. USA 2014, 110, 7631–7635. [Google Scholar] [CrossRef]
- Rossi-Rodrigues, B.C.; Brochetto-Braga, M.R.; Tauk-Tornisielo, S.M.; Carmona, E.C.; Arruda, V.M.; Chaud Netto, J. Comparative growth of Trichoderma strains in different nutritional sources, using bioscreen c automated system. Braz. J. Microbiol. 2009, 40, 404–410. [Google Scholar] [CrossRef] [PubMed]
- Guo, Y.; Ghirardo, A.; Weber, B.; Schnitzler, J.-P.; Benz, J.P.; Rosenkranz, M. Trichoderma species differ in their volatile profiles and in antagonism toward ectomycorrhiza Laccaria bicolor. Front. Microbiol. 2019, 10, 891. [Google Scholar] [CrossRef] [PubMed]
- Elsherbiny, A.E.; Amin, B.H.; Aleem, B.; Kingsley, K.L.; Bennett, J.W. Trichoderma volatile organic compounds as a biofumigation tool against late blight pathogen Phytophthora infestans in postharvest potato tubers. J. Agric. Food Chem. 2020, 68, 8163–8171. [Google Scholar] [CrossRef] [PubMed]
- Montanari, R.M.; Barbosa, L.C.A.; Demuner, A.J.; Silva, C.J.; Carvalho, L.S.; Andrade, N.J. Chemical composition and antibacterial activity of essential oils from verbenaceae species: Alternative sources of (E)-caryophyllene and germacrene-D. Quím. Nova 2011, 34, 1550–1555. [Google Scholar] [CrossRef]
- Santos, T.G.; Laemmle, J.; Rebelo, R.A.; Dalmarco, E.M.; Cruz, A.B.; Schmit, A.P. Chemical composition and antimicrobial activity of Aloysia gratíssima (Verbenaceae) leaf essential oil. J. Essent. Oil Res. 2015, 27, 125–130. [Google Scholar] [CrossRef]
- Nieto-Jacobo, M.F.; Steyaert, J.M.; Salazar-Badillo, F.B.; Nguyen, D.V.; Rostás, M.; Braithwaite, M.; De Souza, J.T.; Jimenez-Bremont, J.F.; Ohkura, M.; Stewart, A.; et al. Environmental growth conditions of Trichoderma spp. affects indole acetic acid derivatives, volatile organic compounds, and plant growth promotion. Front. Plant Sci. 2017, 8, 102. [Google Scholar] [CrossRef]
- Wonglom, P.; Daengsuwan, W.; Ito, S.; Sunpapao, A. Biological control of Sclerotium fruit rot of snake fruit and stem rot of lettuce by Trichoderma sp. T76-12/2 and the mechanism involved. Physiol. Mol. Plant Pathol. 2019, 107, 1–7. [Google Scholar] [CrossRef]
- Intana, W.; Wonglom, P.; Dy, K.S.; Sunpapao, A. Development of a novel emulsion formulation of Trichoderma asperelloides PSU-P1 conidia against stem canker on dragon fruit caused by Neoscytalidium dimidiatum. Microbiol. Res. 2023, 14, 1139–1149. [Google Scholar] [CrossRef]
- Wang, H.; Tang, W.; Mao, Y.; Ma, S.; Chen, X.; Shen, X.; Yin, C.; Mao, Z. Isolation of Trichoderma virens 6PS-2 and its effects on Fusarium proliferatum f. sp. malus domestica MR5 related to apple replant disease (ARD) in China. Hortic. Plant J. 2022; in press. [Google Scholar] [CrossRef]

Disclaimer/Publisher’s Note: The statements, opinions and data contained in all publications are solely those of the individual author(s) and contributor(s) and not of MDPI and/or the editor(s). MDPI and/or the editor(s) disclaim responsibility for any injury to people or property resulting from any ideas, methods, instructions or products referred to in the content. |
© 2024 by the authors. Licensee MDPI, Basel, Switzerland. This article is an open access article distributed under the terms and conditions of the Creative Commons Attribution (CC BY) license (https://creativecommons.org/licenses/by/4.0/).
Share and Cite
Athinuwat, D.; Ruangwong, O.-U.; Harishchandra, D.L.; Pitija, K.; Sunpapao, A. Biological Control Activities of Rhizosphere Fungus Trichoderma virens T1-02 in Suppressing Flower Blight of Flamingo Flower (Anthurium andraeanum Lind.). J. Fungi 2024, 10, 66. https://doi.org/10.3390/jof10010066
Athinuwat D, Ruangwong O-U, Harishchandra DL, Pitija K, Sunpapao A. Biological Control Activities of Rhizosphere Fungus Trichoderma virens T1-02 in Suppressing Flower Blight of Flamingo Flower (Anthurium andraeanum Lind.). Journal of Fungi. 2024; 10(1):66. https://doi.org/10.3390/jof10010066
Chicago/Turabian StyleAthinuwat, Dusit, On-Uma Ruangwong, Dulanjalee L. Harishchandra, Kitsada Pitija, and Anurag Sunpapao. 2024. "Biological Control Activities of Rhizosphere Fungus Trichoderma virens T1-02 in Suppressing Flower Blight of Flamingo Flower (Anthurium andraeanum Lind.)" Journal of Fungi 10, no. 1: 66. https://doi.org/10.3390/jof10010066
APA StyleAthinuwat, D., Ruangwong, O.-U., Harishchandra, D. L., Pitija, K., & Sunpapao, A. (2024). Biological Control Activities of Rhizosphere Fungus Trichoderma virens T1-02 in Suppressing Flower Blight of Flamingo Flower (Anthurium andraeanum Lind.). Journal of Fungi, 10(1), 66. https://doi.org/10.3390/jof10010066

